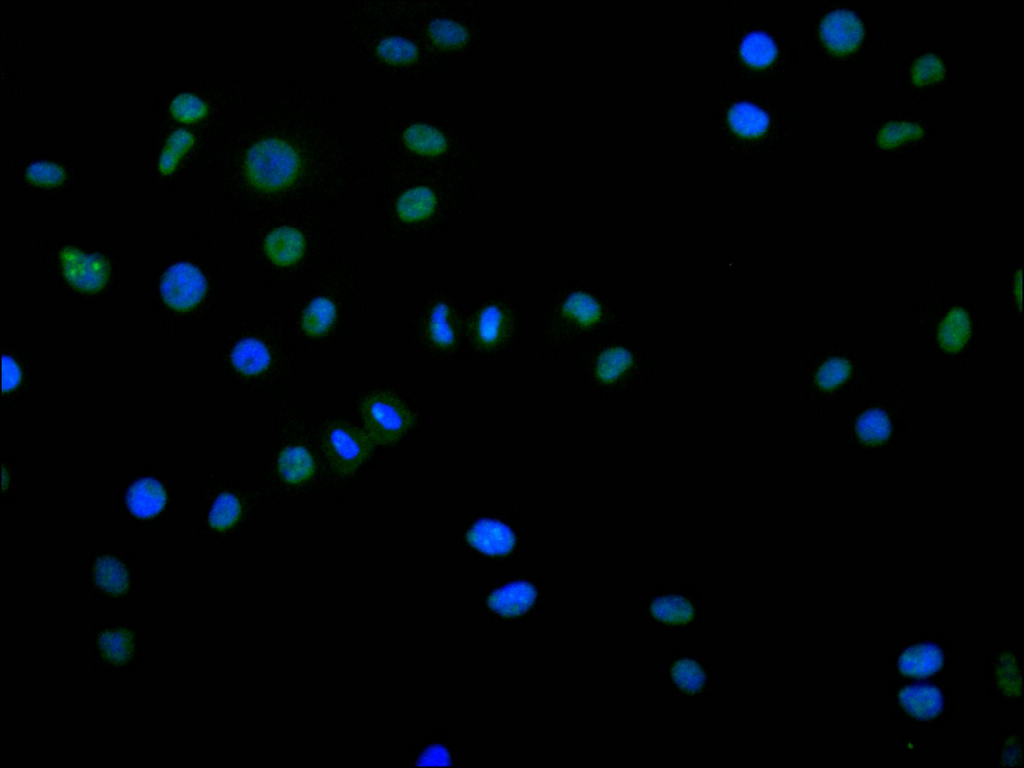

DDX17 Recombinant Monoclonal Antibody
-
中文名稱:DDX17 Recombinant Monoclonal Antibody
-
貨號(hào):CSB-RA033630A0HU
-
規(guī)格:¥1320
-
圖片:
-
Immunofluorescence staining of Hela cell with CSB-RA033630A0HU at 1:50, counter-stained with DAPI. The cells were fixed in 4% formaldehyde, permeabilized using 0.2% Triton X-100 and blocked in 10% normal Goat Serum. The cells were then incubated with the antibody overnight at 4°C. The secondary antibody was Alexa Fluor 488-congugated AffiniPure Goat Anti-Rabbit IgG(H+L).
-
-
其他:
產(chǎn)品詳情
-
Uniprot No.:
-
基因名:DDX17
-
別名:Probable ATP-dependent RNA helicase DDX17 (EC 3.6.4.13) (DEAD box protein 17) (DEAD box protein p72) (DEAD box protein p82) (RNA-dependent helicase p72), DDX17
-
反應(yīng)種屬:Human
-
免疫原:A synthesized peptide from human DDX17 protein
-
免疫原種屬:Homo sapiens (Human)
-
標(biāo)記方式:Non-conjugated
-
克隆類型:Monoclonal
-
抗體亞型:Rabbit IgG
-
純化方式:Affinity-chromatography
-
克隆號(hào):9E6
-
濃度:It differs from different batches. Please contact us to confirm it.
-
保存緩沖液:Preservative: 0.03% Proclin 300
Constituents: 50% Glycerol, 0.01M PBS, PH 7.4 -
產(chǎn)品提供形式:Liquid
-
應(yīng)用范圍:ELISA, IF
-
推薦稀釋比:
Application Recommended Dilution IF 1:50-1:200 -
Protocols:
-
儲(chǔ)存條件:Upon receipt, store at -20°C or -80°C. Avoid repeated freeze.
-
貨期:Basically, we can dispatch the products out in 1-3 working days after receiving your orders. Delivery time maybe differs from different purchasing way or location, please kindly consult your local distributors for specific delivery time.
-
用途:For Research Use Only. Not for use in diagnostic or therapeutic procedures.
相關(guān)產(chǎn)品
靶點(diǎn)詳情
-
功能:As an RNA helicase, unwinds RNA and alters RNA structures through ATP binding and hydrolysis. Involved in multiple cellular processes, including pre-mRNA splicing, alternative splicing, ribosomal RNA processing and miRNA processing, as well as transcription regulation. Regulates the alternative splicing of exons exhibiting specific features. For instance, promotes the inclusion of AC-rich alternative exons in CD44 transcripts. This function requires the RNA helicase activity. Affects NFAT5 and histone macro-H2A.1/MACROH2A1 alternative splicing in a CDK9-dependent manner. In NFAT5, promotes the introduction of alternative exon 4, which contains 2 stop codons and may target NFAT5 exon 4-containing transcripts to nonsense-mediated mRNA decay, leading to the down-regulation of NFAT5 protein. Affects splicing of mediators of steroid hormone signaling pathway, including kinases that phosphorylates ESR1, such as CDK2, MAPK1 and GSK3B, and transcriptional regulators, such as CREBBP, MED1, NCOR1 and NCOR2. By affecting GSK3B splicing, participates in ESR1 and AR stabilization. In myoblasts and epithelial cells, cooperates with HNRNPH1 to control the splicing of specific subsets of exons. In addition to binding mature mRNAs, also interacts with certain pri-microRNAs, including MIR663/miR-663a, MIR99B/miR-99b, and MIR6087/miR-6087. Binds pri-microRNAs on the 3' segment flanking the stem loop via the 5'-[ACG]CAUC[ACU]-3' consensus sequence. Required for the production of subsets of microRNAs, including MIR21 and MIR125B1. May be involved not only in microRNA primary transcript processing, but also stabilization. Participates in MYC down-regulation at high cell density through the production of MYC-targeting microRNAs. Along with DDX5, may be involved in the processing of the 32S intermediate into the mature 28S ribosomal RNA. Promoter-specific transcription regulator, functioning as a coactivator or corepressor depending on the context of the promoter and the transcriptional complex in which it exists. Enhances NFAT5 transcriptional activity. Synergizes with TP53 in the activation of the MDM2 promoter; this activity requires acetylation on lysine residues. May also coactivate MDM2 transcription through a TP53-independent pathway. Coactivates MMP7 transcription. Along with CTNNB1, coactivates MYC, JUN, FOSL1 and cyclin D1/CCND1 transcription. Alone or in combination with DDX5 and/or SRA1 non-coding RNA, plays a critical role in promoting the assembly of proteins required for the formation of the transcription initiation complex and chromatin remodeling leading to coactivation of MYOD1-dependent transcription. This helicase-independent activity is required for skeletal muscle cells to properly differentiate into myotubes. During epithelial-to-mesenchymal transition, coregulates SMAD-dependent transcriptional activity, directly controlling key effectors of differentiation, including miRNAs which in turn directly repress its expression. Plays a role in estrogen and testosterone signaling pathway at several levels. Mediates the use of alternative promoters in estrogen-responsive genes and regulates transcription and splicing of a large number of steroid hormone target genes. Contrary to splicing regulation activity, transcriptional coregulation of the estrogen receptor ESR1 is helicase-independent. Plays a role in innate immunity. Specifically restricts bunyavirus infection, including Rift Valley fever virus (RVFV) or La Crosse virus (LACV), but not vesicular stomatitis virus (VSV), in an interferon- and DROSHA-independent manner. Binds to RVFV RNA, likely via structured viral RNA elements. Promotes mRNA degradation mediated by the antiviral zinc-finger protein ZC3HAV1, in an ATPase-dependent manner.
-
基因功能參考文獻(xiàn):
- This study demonstrated that the association of DDX17delG in the treatment-resistant ophthalmoplegic subphenotype of myasthenia gravis. PMID: 28673556
- Mutant p53 protein (Mutp53) binds and sequesters RNA helicases p72/82 from microprocessor causing an attenuation of microRNAs (miRNAs) maturation. PMID: 26996669
- DDX17 contributes to acquired gefitinib resistance through exportin/importin-dependent cytoplasmic shuttling and activation of beta-catenin in non-small lung cancer cells. PMID: 28259822
- The miRNA biogenesis factors, DDX17 and KHSRP, regulate the protein level of Ago2 in human cells. PMID: 27478153
- DDX17 is a Sox2-binding protein in estrogen receptor-positive breast cancer; in reporter responsive (RR) cells but not reporter unresponsive (RU) cells, DDX17 enhances the tumorigenic and stem-like features of Sox2 by promoting its binding to its target genes PMID: 26569340
- Overexpression of p72 decreased Beclin1 expression partially by increasing miR-34-5p and miR-5195-3p expression in glioma cells. PMID: 27301285
- Systematic Determination of Human Cyclin Dependent Kinase (CDK)-9 Interactome Identifies Novel Functions in RNA Splicing Mediated by the DDX5 and DDX17 RNA Helicases PMID: 26209609
- Downregulation of DDX5 and DDX17 protein expression during myogenesis and epithelial-to-mesenchymal transdifferentiation contributes to the switching of splicing programs during these processes. PMID: 24910439
- Depletion of DDX17 but not the related helicase DDX5 increased Rift Valley fever virus replication in human cells. PMID: 25126784
- DDX17 promotes the production of HIV-1 infectious particles by modulating HIV-1 RNA metabolism. PMID: 23769241
- Data indicate that transcriptional coregulator ddx5/ddx17 RNA helicases can simultaneously regulate the transcriptional activity and alternative splicing of NFAT5 transcription factor. PMID: 22266867
- RNA helicases Ddx17 and Ddx5 contribute to tumor-cell invasiveness by regulating alternative splicing of several DNA- and chromatin-binding factors, including the macroH2A1 histone. PMID: 23022728
- Pleiotropic effects of p300-mediated acetylation on p68 and p72 RNA helicase. PMID: 20663877
- Short-term exercise resulted in a significant increase of mRNA expression of genes encoding proteins involved in the formation of precatalytic splisosome: DDX17. PMID: 19902070
- Results show that the abundant DEAD-box RNA helicase p72, but not its close relative p68, affects the splicing of alternative exons containing AC-rich exon enhancer elements. PMID: 12138182
- has a role in pre-mRNA splicing, in particular, at the early stages of the splicing reaction involving U1snRNP PMID: 12193588
- p72 is an important transcriptional regulator, functioning as a co-activator and/or co-repressor depending on the context of the promoter & the transcriptional complex. AA 1-474 of p72 can repress transcription as well as the full-length protein. PMID: 15298701
- p72 RNA helicase may not only be involved in the p53-Mdm2 regulatory loop, but also profoundly impact on the transcriptome through various CBP/p300 and P/CAF interacting proteins. PMID: 17226766
- p68/p72 may contribute to colon cancer formation by directly up-regulating proto-oncogenes and indirectly by down-regulating the growth suppressor p21(WAF1/CIP1). PMID: 17699760
- The DEAD-box proteins p68(Ddx5) and p72(Ddx17) were used as models for this coexpression frequency analysis as there are defined functions for these proteins in splicing and transcription. PMID: 18005418
- p72 is required for the optimal activity of zinc-finger antiviral protein PMID: 18334637
- putative AR co-factor, DDX17, is known to be a co-factor for estrogen receptor alpha (ERalpha), but has never been associated PMID: 19059367
- A crucial role for p72 in ERalpha co-activation and oestrogen-dependent cell growth. PMID: 19718048
- Alternate protein isoforms arise through the use of a non-AUG (CUG) and a downstream in-frame AUG translation initiation codons. PMID: 11675387
顯示更多
收起更多
-
亞細(xì)胞定位:Nucleus. Nucleus, nucleolus. Cytoplasm, cytosol.
-
蛋白家族:DEAD box helicase family, DDX5/DBP2 subfamily
-
組織特異性:Widely expressed. Low expression, if any, in normal colonic epithelial cells (at protein level). Levels tend to increase during colon cancer progression, from very low in benign hyperplastic polyps to very high in tubular and villous adenomas.
-
數(shù)據(jù)庫(kù)鏈接:
Most popular with customers
-
-
Phospho-YAP1 (S127) Recombinant Monoclonal Antibody
Applications: ELISA, WB, IHC
Species Reactivity: Human
-
-
-
-
-
-